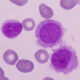
Leucemia de células pilosas

Los linfomas no Hodgkin (LNH) son un conjunto diverso de enfermedades malignas del sistema linfático caracterizadas por la proliferación anormal de linfocitos. Este grupo de cánceres presenta una amplia variabilidad en términos de presentación clínica y curso, que puede oscilar desde formas indolentes, con un crecimiento lento y progresión más gradual, hasta variantes altamente agresivas, con un rápido avance y pronóstico menos favorable.
La investigación en biología molecular ha revelado importantes pistas sobre la patogénesis de los LNH. Uno de los mecanismos comunes involucra translocaciones cromosómicas equilibradas, donde un oncogén (un gen que puede causar cáncer) se fusiona con un gen de inmunoglobulina en el caso de linfomas de células B, o con el gen del receptor de células T u otro gen relacionado en linfomas de células T. Esta fusión conduce a la sobreexpresión del oncogén, lo que contribuye al desarrollo del linfoma.
Por ejemplo, en el linfoma de Burkitt, se ha identificado una característica anomalía citogenética que implica una translocación entre los brazos largos de los cromosomas 8 y 14. Esta translocación resulta en la yuxtaposición del protooncogén c-myc con el locus de la cadena pesada de inmunoglobulina en el cromosoma 14, lo que conduce a una sobreexpresión de c-myc. Esta sobreexpresión está asociada con la transformación maligna y la proliferación excesiva de células B.
En el caso del linfoma folicular, se observa una translocación característica conocida como t(14;18), que conduce a la sobreexpresión del gen bcl-2. Esta sobreexpresión de bcl-2 confiere a las células B una mayor protección contra la apoptosis, que es el mecanismo normal de muerte celular programada. Esta capacidad de evitar la muerte celular contribuye al crecimiento descontrolado de las células B y al desarrollo del linfoma folicular.
Es importante destacar que aproximadamente el 85% de los LNH son de origen B y el 15% son de origen T o células asesinas naturales (NK). Aunque estos linfomas representan un conjunto diverso de enfermedades, tradicionalmente se han clasificado en dos categorías principales según su comportamiento clínico y patológico: los indolentes (de bajo grado) y los agresivos (de grado intermedio o alto). Esta clasificación proporciona una base para la comprensión del curso clínico de la enfermedad y guía las decisiones terapéuticas.
Hallazgos clínicos
La linfoadenopatía, o agrandamiento de los ganglios linfáticos, es una característica común en los pacientes con linfomas no Hodgkin (LNH). Esta manifestación se debe a la proliferación anormal de células linfoides malignas en los ganglios linfáticos, lo que conduce a su agrandamiento y a menudo a su palpabilidad durante la exploración física. Los ganglios linfáticos afectados pueden localizarse tanto de forma periférica (por ejemplo, en el cuello, las axilas o la ingle) como de forma central, en áreas como el retroperitoneo, el mesenterio y la pelvis.
Los linfomas indolentes, caracterizados por un crecimiento lento y progresión gradual, tienden a estar diseminados en el momento del diagnóstico. Además, la afectación de la médula ósea es común en estos casos, lo que puede contribuir aún más a la linfoadenopatía generalizada. Muchos pacientes con LNH también experimentan síntomas constitucionales, como fiebre, sudores nocturnos profusos y pérdida de peso significativa (superior al 10% del peso corporal previo), que se conocen como «síntomas B».
En la exploración física, la linfoadenopatía puede manifestarse de diversas formas, ya sea como ganglios aislados o como agrandamiento difuso de múltiples ganglios. Además, la enfermedad puede afectar sitios extraganglionares, lo que significa que puede manifestarse en tejidos y órganos fuera del sistema linfático. Estos sitios extraganglionares pueden incluir la piel, el tracto gastrointestinal, el hígado y la médula ósea, lo que añade una complejidad adicional al cuadro clínico de la enfermedad.
En el caso específico del linfoma de Burkitt, los pacientes tienden a presentar dolor abdominal o sensación de plenitud abdominal debido a la predilección de la enfermedad por esta región del cuerpo. Esto puede estar relacionado con la localización de los ganglios linfáticos afectados en el abdomen, así como con la posible afectación de otros órganos abdominales por parte del linfoma.
Exámenes complementarios
- Estadificación: Una vez que se ha establecido el diagnóstico patológico de linfoma, es crucial determinar la extensión y la gravedad de la enfermedad, lo que se conoce como estadificación. Este proceso ayuda a los médicos a planificar el tratamiento adecuado y a prever el pronóstico del paciente. La estadificación generalmente implica la realización de varias pruebas, como una tomografía por emisión de positrones/tomografía computarizada (PET/TC) de cuerpo entero, una biopsia de médula ósea y, en ciertos casos, una punción lumbar. La PET/TC proporciona información sobre la distribución de la enfermedad en todo el cuerpo, mientras que la biopsia de médula ósea evalúa la presencia de células linfomatosas en la médula ósea. La punción lumbar se realiza específicamente en pacientes con linfoma de grado alto o linfoma de grado intermedio con características de alto riesgo para evaluar la posible participación del sistema nervioso central.
- Sangre periférica y médula ósea: A pesar de la afectación extensa de la médula ósea por el linfoma, los resultados de los análisis de sangre periférica suelen ser normales, y las células linfomatosas circulantes son poco comunes. La afectación de la médula ósea se detecta mejor mediante una biopsia de médula ósea, donde se pueden observar agregados de células linfoides monoclonales paratrabeculares, lo que confirma la extensión de la enfermedad en este sitio.
- Involucramiento de las meninges y citología del líquido cefalorraquídeo: En algunos casos de linfomas de grado alto, las meninges pueden estar afectadas, lo que se evidencia por la presencia de células malignas en el líquido cefalorraquídeo (LCR). Para evaluar esto, se realiza una punción lumbar para obtener una muestra de LCR, que luego se analiza en busca de células malignas en la citología.
- Lactato deshidrogenasa (LD) sérica: La LD sérica es un marcador pronóstico útil en el linfoma, y su nivel se utiliza en la estratificación de riesgos del tratamiento. Niveles elevados de LD pueden indicar una mayor carga tumoral y pronóstico menos favorable, lo que puede influir en las decisiones terapéuticas.
- Diagnóstico por biopsia de tejido: El diagnóstico definitivo del linfoma se realiza mediante una biopsia de tejido, que implica la obtención de una muestra de tejido afectado para su análisis patológico. Aunque la aspiración con aguja puede proporcionar evidencia inicial para el linfoma no Hodgkin, se requiere una biopsia ganglionar o de tejido extraganglionar involucrado para un diagnóstico y clasificación precisos. Esto se debe a que la biopsia permite una evaluación más detallada de la arquitectura celular y tisular, así como de las características moleculares específicas del linfoma, lo que es fundamental para determinar el curso clínico y el tratamiento óptimo.

Síguenos en X: @el_homomedicus y @enarm_intensivo Síguenos en instagram: homomedicus y en Treads.net como: Homomedicus